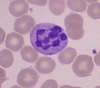
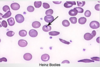

heme portion Flashcards
(72 cards)
Iron Deficient Anemia

what size and color? what two unique characteristics about this cell type hint: shape? what are 3 main causes? what should you always suspect? what are 5 unique presentations you might see on PE? what is the treatment? for how long?
hypochromic, microcytic anemia (since no iron to give shape or color)
anisocytosis (unequal size) and piokilocytosis (tear drop shapped)
common causes: blood loss (menses, occult from colon, esophagus, stomach), pregnancy, vegan diet
**always suspect malignancy**
pica (eating dirt/paint), cheilosis, koilonchia “spoon nails”, glottitis “smooth tongue”, esophageal webs, pallor, tachycardia
treatment: Ferrous sulfate 325 mg 3x a day, vitamin C to make absorb better and uptitrate, OR GLUCONATE which is IM or IV
TREAT FOR 6 MONTHS!!

what can cause blood loss in iron deficient anemia? 4 things
GI blood loss from NSAIDS, PUD, cancer
blood donation
trauma
menses
what would you see on the labs for iron deficient anemia?
5 things!
- Low Iron
- High TIBC (since none to bind, very avaliable)
- low ferritin (since none to store)
- low reticulocyte
- hypochromic, microcytic cells
Vitamin B12 deficient anemia
what size and color at these RBC? what factor sets this appart from folate deficient anemia and what are the 5 presentations? what are the 6 things that can cause this and where are the two general sections of the GI system that are effected? what are the 4 important lab results that point to this?
macrocytic/megloblastic anemia, normochromic
can occur from vegan diet, bariatric gastric surgery (MOST COMMON WAY TODAY), ilium resection, chrons disease, pernicious anemia (no intrinsic factor), gastritics
neurologic symptoms, stocking glove paresthesia, loss of position, vibratory sense, balance, glottitis
On lab exams find:
1. antibodies for intrinsic factor
2. MCV >103
2. serum b12 low
4. multinucleated neutrophils!!! 5-6 lobes
Tx: oral supplement or cyanocobalamin nasal spray
what is the number one cause of iron deficient anemia? what are 3 other causes?
- blood loss! need to find the cause!!
2. malignancy! need to think about this
- dietary, vegan!! less common
- poor iron absorption/ trauma
explain how B12 is absorbed and which conditions effect these stages?
B12 is bound to intrinsic factor that prevents it from being absorbed until it reached the ilieum
chrons disease, ilium ressection effect: where it is absorbed
gastric surgery, pernicious anemia, gastritis effect: where intrinsic factor is made
***both of these cause B12 deficiency either in its protection or its absorption!***
what cells produce intrinsic factor that are important for the absorption of B12? where are they located?
parietal cells in the stomach
gastritis PUD can prevent this from working
no intrinsic factor, no absorption
what are three things can cause poor absorption of B12 for anemia?
alcoholism
fish tapeworm
elevated LDH
what are the 3 treatment options for B12 deficient anemia?
- life long vitamin B supplement IM monthly (1000 ug)
2. cyanocobalasmin nasal spray
***neuro symptoms are reversible if treated within 6 months***
explain the schillings test and what it tells you?
tells you which there is a B12 deficiency
Normally, give B12 IM injection so the body is saturday, then give oral B12 radioative, it will be absorbed by the body and AT LEAST 10% excreted in the urine since it isn’t needed. This means uptake is normal and working!!
if pernicious anemia or imparied absorption: LESS than 10% in the urine since not absorbed or partially from bowel
if give intrinsic factor and see B12 in the urine then absorption has improved: pernicious anemia
if no B12 in the uring after intrinsic factor then: problem with absorption in illium, not intrinsic factor
sickle cell anemia
what is the inhertiance pattern? what is the difference between heterozygous/homozygous? when do the problems first occur? where is the mutation? what are 8 things that can prompt sickeling? what are 7 presentations you can see with this disorder?
autosomal recessive
heterozygous 1 Hb S gene: 40%
homozygous 2 Hb SS gene: 80-95%
problems start about 6 months after birth during transition from Hb-F to Hb
mutation in B chain, cause it to sickle under/from:
dehydration, hypoxia, acidosis, infection, temp changes, exertion, alcohol, medical procedures
causes acute painful syndrome, acute chest syndrome, splenic sequestration, aplastic crisis, hemolytic crisis, hand foot disease, “silent” cerebral infarction (35%, subtle but permanent)
what is this and what condition do you commonly see this with?

hand and foot syndrome seen with sickle cell
commonly the first presentation
soft tissue swelling with new bone formation and moth eaten lytic process at proximal aspect of fourth phalanx
no leukocytosis or erythema with the swelling
explain the pathphys of sickle cell
increased RBC destruction
inability to maintain hemoglobin
sickling of cells=increased blood viscosity and ostruction
MORE FRAGIL=hemolysis!
what is the life expectancy for a pt with sickle cell?
40-50 years
die young from infections
Explain actute painful crisis and acute chest syndrome seen in sickle cell pts
acute painful crisis:
excrutiating, can occur anywhere
acute causes vasco occlusion and ishchemia
acute chest syndrome
25% of deaths!
respiratory distress
explain aplastic crisis seen in sickle cell and the five things that can cause it?
stop of RBC production, and since their RBC live so much short ~20 days, they get EXTREME drop in hemoglobin causing aplastic crisis
parvarovirus B19, infection, bone marrow toxins HPV, folic acid deficiency
what do sickle cell patients need to avoid?
altitiudes over 7,000 feet and deep sea diving!
induces sickling
what do you see for lab results for a patient with sickle cell? 6 things!!
- howell jolly bodies
2. Hgb S >50%
3. hb 6-8
4. RBC last 10-20 days
- high reticulocytes
- high ferritin/serum bilirubin
what treatment options are avaliable for someone with sickle cell?
- hydration
- pain meds!!
- transfusion
- folate supplementation
- iron chelation if Fe overload
- preventative vaccines for S. pneumonia, H. influenzae
-prophylatic penicillin from birth to 6 years
hydroxyurea
explain hydroxyurea for sickle cell patients 3 things
- Decrease DNA synthesis
- Inhibit sickling
- Increase Hb F inhibits Hb sickling
**prevents complications and increases life span**
what are sickle cell patients are increased risk for?
(6 things)
- infection with encapsulated organisms
- aseptic necrosis
- CVA
- chronic leg ulcers
- splenic infarc THESE PATIENTS ARE ASPLENIC (DON’T HAVE A SPLEEN THAT WORKS WELL SO NEED TO MAKE SURE THEY ARE VACCINATED ESP AGAINST STREP PNEUMONIA
- retinopathy
explain HbSC and HbSS in sickle cell
Hb SC is the trait for sickle cell, heterozygous and range of symptoms vary
Hb SS the disease for sickle cell, homozygous, severe disease
folate deficiency
what is the most common cause of this? what are four things that can cause this? what size are the cells? what two things do you see on the labs? what 5 drugs can cause this? what is the treatment?
most often caused by poor dietary intake, low fruits and veggies
absorbed in the ileum
macrocytic, hypersegmented PMN, folate
alcoholics, defective absorption (chrons, ulcerative collitis), pregnancy, folic acid antagonist drugs
drugs: methotrexate, alcohol, phenytoin, trimethoprim-sulfamethozole, sulfasalazine
tx: 1 mg folic acid a day
what are lymphomas? where are they?
localized to lymphnodes
malignancy of matured lymphcytes not precursor cells
arises in the PERIPHERY, then can spread to bone marrow